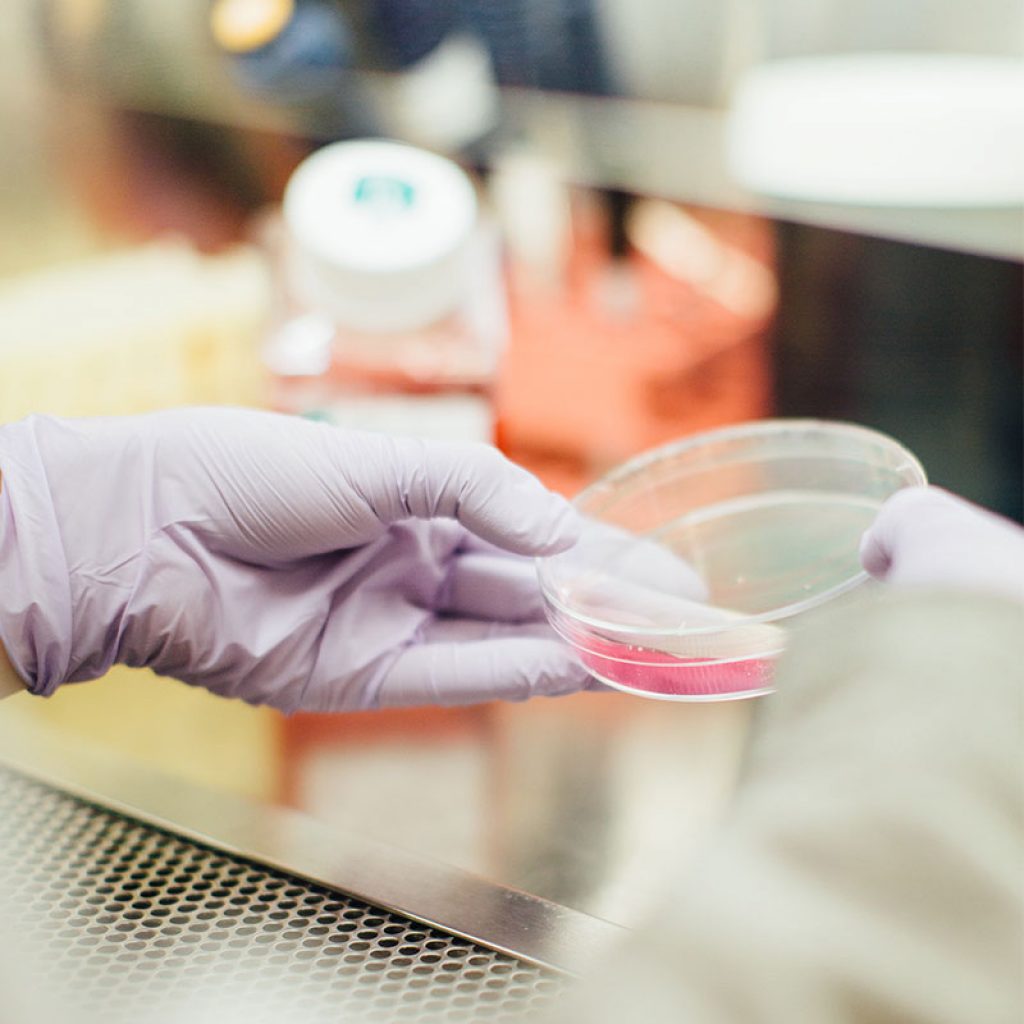
agency-for-words-a4words-sector-ciencias-salud

Agency for Words
agencia especializada en traducción y soluciones lingüísticas

AGENCIA ESPECIALIZADA
Traducción y soluciones lingüísticas
Agency for Words es una agencia especializada en traducción y soluciones lingüísticas. Nuestro proceso de trabajo 100 % online, acompañado de una red de traductores y editores nativos, garantiza plazos de entrega ágiles, evitando así intermediarios.


CONOCE NUESTRAS
Soluciones lingüísticas
Traducciones juradas
Traducción oficial de documentos por traductores jurados.
Traducción profesional
Traducción de textos y documentos por traductores profesionales nativos.
Edición & proofreading
Edición de traducciones para evitar que existan errores de interpretación.
Localización de textos
Adaptación de textos teniendo en cuenta aspectos culturales, funcionales, etc.
Postedición o MTPE
Revisión y corrección de textos generados por traducción automática.
Maquetación Multilingüe
Traducción y maquetación de textos en los propios archivos de diseño.
NUESTRO EQUIPO SE ESPECIALIZA EN DIVERSOS
Sectores e industrias
TRADUCTORES NATIVOS
Hablamos tu mismo idioma
Trabajamos con y para nuestros clientes. Nuestro objetivo es convertirnos en tus socios y colaboradores para ayudarte a lograr tus objetivos con nuestras soluciones y servicios de traducción en español, inglés, portugués, francés, alemán, sueco, danés, noruego y finlandés.
Para otros idiomas, consulta con nuestro equipo para encontrar la solución a tu medida.










TRADUCTORES FREELANCE
¿Quieres formar parte de nuestro equipo?
Agency for Words es una agencia boutique en crecimiento y buscamos traductores y editores freelancers nativos con ganas de vivir nuevos desafíos y retos en la traducción, edición y localización de textos.

PARA MÁS INFORMACIÓN
Déjanos un mensaje
No dudes en ponerte en contacto con nosotros para solicitar más información sobre un proyecto o para formar parte de nuestro equipo.
(+34) 666 871 445
DIRECCIÓN:
Calle Alhamar 4, 8º Pta. 4.
Calahonda, Mijas.
29649
Málaga – España